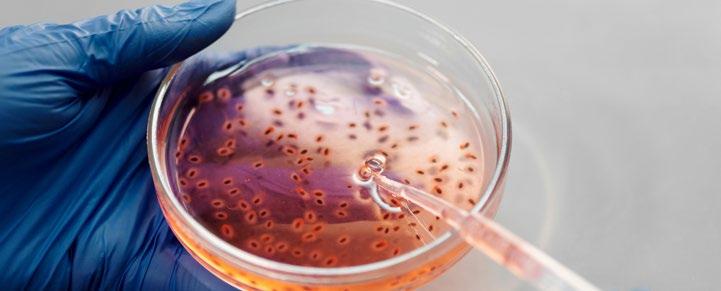

MÉDICO
CLÍNICA BUPA
SANTIAGO REALIZA INNOVADORA CIRUGÍA VASCULAR BAJO LA DIRECCIÓN DEL DR. MARTÍN CUBELLI
INTEGRAMÉDICA PLAZA VESPUCIO PONE EN MARCHA
PROGRAMA
PILOTO TEA
CLÍNICA BUPA REÑACA DESTACADA EN RANKING WORLD BEST HOSPITALS 2024
CLÍNICA BUPA
ANTOFAGASTA Y SU CRUCIAL APOYO EN EL OPERATIVO MÉDICO «MANOS QUE AYUDAN»

MUNDO N° 46 - Marzo 2024 Bupa Chile | Clínica Bupa Santiago | Bupa Lab | IntegraMédica | Clínica Bupa Reñaca | Clínica Bupa Antofagasta
Hemos comenzado un año lleno de actividades y avances que nos enorgullecen, muchos de los cuales vemos publicados en esta edición de nuestra Revista Mundo Médico mostrando la excelencia, compromiso y calidad de nuestro mundo clínico.

Y ahora, iniciando ya el segundo trimestre, nos enfrentamos a una nueva Campaña de Invierno en la que debemos prepararnos preventiva y proactivamente para cuidar a nuestros pacientes, a nuestro personal y a nosotros mismos, y poder responder a las necesidades asistenciales.
Como siempre, lo primero es prevenir, siendo la vacunación la principal estrategia para ello; este año, junto a las vacunas anti-Influenza y SARS CoV-2, se agrega la buena noticia de la disponibilidad de Anticuerpo monoclonal Nirsevimab para prevenir morbilidad grave y mortalidad por VRS en recién nacidos y lactantes. Con esto se espera una reducción importante en la necesidad de hospitalizaciones en ese rango de edad. Chile es el primer país del hemisferio sur que cuenta con este recurso.
Y una vez más destacamos la importancia de la vacunación del personal de salud, que es esencial tanto por la protección personal, como por la protección de los pacientes y para la continuidad de los servicios.
Otras medidas preventivas asociadas son la educación a las personas, -en especial respecto de evitar aglomeraciones, lavado de manos, uso de mascarilla en caso necesario y consulta precoz en caso de síntomas de alerta- y el refuerzo de las actividades de los equipos de IAAS en los centros asistenciales.
La prevención secundaria se basa principalmente en el refuerzo de los sistemas de pesquisa y de diagnóstico para detección y manejo precoz de las infecciones respiratorias, en el control preventivo de la población con patologías crónicas y en la preparación y refuerzo de los servicios asistenciales tanto ambulatorios como hospitalarios y la disponibilidad de servicios de telemedicina.
Estas medidas son de aplicación general y pueden ser reforzadas y complementadas desde el Ministerio de Salud con otras medidas específicas de acuerdo con la evolución que muestre la epidemia respiratoria de invierno este año.
Como red Bupa estamos preparados una vez más para participar de la campaña nacional y cumplir así nuestra misión de cooperar a vidas más largas, sanas y felices y un mundo mejor. Y para ello, sin duda, los equipos de salud son los protagonistas en cada campaña de invierno; con su esfuerzo, cumplimiento, cuidado y ejemplo marcan la diferencia.
¡Contamos con todos!
DRA. PAULINA GÓMEZ
Gerente Médico Corporativo Bupa Chile
COMITÉ EDITORIAL: Dra. Paulina Gómez, Dr. Ignacio Garcia-Huidobro, Dr. Julio Arias, Dr. Manuel González, Dr. Sebastián Carvajal, Dr. Daniel Jerez, Dra. Marcela Henríquez, Dr. José Patricio Miranda, Dra. María Victoria Moreno, Pamela Contador, Francisca Chinchilla, EU Ana María Quezada. EDICIÓN PERIODÍSTICA Y DISEÑO: MAB Comunicaciones.
Bupa Chile 2 |
Dr. Juan Francisco Aguirre asume como Responsable de Calidad del segmento Clínicas Bupa Chile 01
Bupa firma convenio con FONASA para otorgar atenciones de salud sin costo a personas damnificadas por incendios forestales en la Región de Valparaíso
Clínicas Bupa Chile se prepara para la campaña de invierno
¡Preparémonos para el invierno en Bupa Chile! consejos clave para un invierno saludable
Nuevo punto de atención FONASA en Clínica Bupa Santiago
Conoce al equipo de Cirugía Vascular de Clínica Bupa Santiago
Innovadora cirugía vascular bajo la dirección del Dr. Martín Cubelli
Equipo de Cirugía Maxilofacial publica nueva técnica artroscópica para extracción de disco articular
Comprometidos con la prevención del cáncer cervicouterino
Actualización sobre la detección de virus respiratorios y SARS-CoV-2 en laboratorio Bupa Lab de Bupa Chile
IntegraMédica Plaza Vespucio pone en marcha programa piloto TEA
Dra. Josefina Bascuñán: nueva líder en Gestión Clínica de IntegraMédica
IntegraMédica conmemora el Mes de la Mujer
IntegraMédica
Clínica
ÍNDICE Actividades de Desarrollo Profesional Bupa Chile 2024
desarrolloprofesional@bupa.cl
BUPA CHILE 06 08 10 11
Reversión de Vasectomía
través
microcirugía
a
de
BUPA SANTIAGO 14 15 16 18 20
02 CLÍNICA
Cultivo anaerobio disponible en Bupa Lab 03 BUPA LAB 24 26 28
04 INTEGRAMÉDICA 32 35 37 39 Manejo inicial de shock séptico pediátrico
Alto Las Condes fortalece el diagnóstico por imagen con nuevo resonador 1.5 Tesla
Transformando
05 CLÍNICA BUPA REÑACA 42 43 44
Bupa Antofagasta
crucial
Ayudan» 06 CLÍNICA BUPA ANTOFAGASTA 48 IX Jornadas de Neumología - Presencial III Jornadas de actualización en el manejo de pacientes que viven con sobrepeso y obesidad Bupa Chile – Híbrido 10 de mayo 24 de mayo RECUERDA QUE PUEDES REVIVIR EN BUPAMED: VIII Curso de Pediatía XV Jornada de Riesgo Cardiovascular, Diabetes y Obesidad XIV Jornada de Obstetricia y Ginecología Permanente | Curso Gobierno Clínico | online
Bupa Reñaca destacada en ranking World Best Hospitals 2024
el manejo del dolor: Clínica Bupa Reñaca lidera con la bomba intratecal
Clínica
y su
apoyo en el operativo médico «Manos que
Bupa Chile 4 |
BUPA CHILE 01

BUPA FIRMA CONVENIO CON FONASA PARA OTORGAR ATENCIONES DE SALUD SIN COSTO A PERSONAS DAMNIFICADAS POR INCENDIOS FORESTALES EN LA REGIÓN DE VALPARAÍSO
En Bupa, estamos comprometidos con acercar la salud cada vez a más personas, compromiso que se refuerza y cobra aún más sentido en tiempos de emergencia como la que vive la región de Valparaíso a causa de los incendios.
Es por eso que, con el objetivo de apoyar a las personas que resultaron afectadas por los incendios en la región de Valparaíso y otorgar atenciones de salud oportunas y de calidad, en conjunto con el apoyo del Fondo Nacional de Salud (FONASA) brindaremos atenciones ambulatorias sin costo alguno para el paciente, a los más de 18 mil damnificados que cuentan con Ficha Básica de Emergencia y sean beneficiarios de Fonasa.
Las personas beneficiadas con este convenio podrán acceder a toda nuestra red de Clínicas y Centros Médicos, especialmente #IntegraMédica Viña del Mar y #ClínicaBupaReñaca.
«Más de 18 mil damnificados podrán reconstruir sus vidas con la seguridad de que su salud está en las mejores manos, incluyendo prestaciones en Clínica Bupa Santiago, Reñaca y Antofagasta», expresó el Dr. Ignacio García-Huidobro, Gerente General Clinicas Bupa Chile.
Por su parte, Dra. Paulina Gómez, Gerente Corporativo Médico, hizo énfasis en la red de centros médicos a

disposición. «Gracias a este convenio, podremos otorgar prestaciones médicas ambulatorias sin costo para el paciente, en toda la #RedBupa a lo largo del país, compuesta por nuestras Clínicas Bupa Reñaca, Bupa Santiago y Bupa Antofagasta, junto a los 27 centros médicos de la red IntegraMédica
Más de 18 mil damnificados podrán reconstruir sus vidas con la seguridad de que su salud está en las mejores manos, incluyendo prestaciones en Clínica Bupa Santiago, Reñaca y Antofagasta.
desplegados en 7 regiones, incluyendo la ciudad de Viña del Mar, durante el periodo en que esté vigente la alerta sanitaria».
Con esta alianza, firmada en compañía de Ximena Aguilera, Ministra de Salud, y Camilo Cid, Director Nacional de Fonasa, Bupa Chile se convierte en la
Bupa Chile 6 |

primera red de prestadores privados de salud en aliarse con Fonasa para impulsar un Plan de Apoyo en Salud para las personas damnificadas por los incendios que afectaron a la Región de Valparaíso.
Para acogerse a este beneficio las personas deben estar acreditadas en FONASA en cualquiera de sus tramos: A, B, C o D y, además, contar con su ficha FIBE. Este convenio comprenderá todas las prestaciones ambulatorias de acuerdo con el catálogo suscrito entre FONASA y el prestador.
Este plan de apoyo tendrá vigencia desde el 29 de febrero y hasta el 31 de mayo de 2024, de acuerdo con la alerta sanitaria decretada por el Ministerio de Salud.


Bupa Chile | 7
CLÍNICAS BUPA CHILE SE PREPARA PARA LA CAMPAÑA DE INVIERNO

Con el invierno acercándose, Clínicas Bupa Chile ha estado trabajando incansablemente para garantizar que sus equipos clínicos estén preparados para enfrentar los desafíos que esta temporada trae consigo. Bajo la coordinación de Paola Vallarino, Enfermera Coordinadora de formación clínica del Segmento Clínicas Bupa en Bupa Chile, se han llevado a cabo una serie de iniciativas enfocadas en mejorar la atención y seguridad de nuestros pacientes.


Bupa Chile 8 |


Una de las áreas de enfoque ha sido la preparación del personal en el uso de equipos clínicos esenciales para la atención de pacientes en estado crítico. En Clínica Bupa Santiago, se identificó la necesidad de fortalecer las habilidades del equipo en la utilización de la ventilación mecánica invasiva. Para abordar esta necesidad, se organizaron talleres especializados que permitieron al personal resolver dudas y practicar el armado de estos equipos vitales.
Además, conscientes de la complejidad que representa la ventilación de alta frecuencia oscilatoria (VAFO), especialmente en pacientes pediátricos críticos, se preparó un taller intensivo sobre su armado y uso. Esta capacitación enfatizó la importancia de un conocimiento profundo y una práctica meticulosa para asegurar el manejo competente de esta tecnología avanzada.
En Clínica Bupa Reñaca, la formación se extendió hacia la simulación de escenarios de shock pediátrico, siguiendo la más reciente normativa local. Esta actividad, liderada por destacados instructores como Dr. Iván Manríquez, EU. Gisela Olate y EU. Paola Orrego, no solo profundizó en el conocimiento del nuevo protocolo, sino que también fortaleció el trabajo en equipo, la comunicación efectiva, y la toma de decisiones críticas mediante la práctica en entornos controlados.
Entendiendo la importancia de una visión global de prevención del riesgo, Clínicas Bupa Chile ha adoptado un enfoque integral que incluye la planificación y ejecución de escenarios de simulación clínica. Estos talleres no solo cubren contenido teórico y habilidades técnicas, sino que también promueven el análisis y la reflexión a través de debriefings, facilitando así el desarrollo de habilidades cognitivas avanzadas y garantizando aprendizajes significativos.
Estas iniciativas reflejan el compromiso de Clínicas Bupa Chile con la excelencia en la atención médica, asegurando que nuestro personal no solo esté preparado técnica y teóricamente, sino también equipado para enfrentar los retos prácticos con confianza y competencia. A medida que nos adentramos en la temporada de invierno, podemos estar seguros de que nuestros equipos clínicos están más preparados que nunca para brindar la más alta calidad de atención y seguridad a nuestros pacientes.
Bupa Chile | 9
¡PREPARÉMONOS
PARA EL
INVIERNO EN BUPA CHILE! CONSEJOS CLAVE PARA UN INVIERNO SALUDABLE
Con la llegada del invierno, los desafíos en el ámbito de la salud se multiplican, especialmente cuando hablamos de prevenir las Infecciones Asociadas a la Atención de Salud (IAAS). En Bupa Chile, queremos asegurarnos de que nuestro equipo esté listo y equipado para enfrentar estos retos de la mejor forma. Aquí van algunos consejos prácticos y fáciles de recordar, basados en la última Circular C37 emitida por la Subsecretaría de Redes Asistenciales:

¡LAS MANOS LIMPIAS SALVAN VIDAS! La higiene de manos nunca pasa de moda. Utiliza soluciones a base de alcohol o, si están visiblemente sucias, opta por agua y jabón. Recuerda: antes y después de cualquier interacción, tus manos deben estar impecables.
LA ELEGANCIA DE ESTORNUDAR: Siempre utiliza el pliegue del codo o un pañuelo desechable. Y si una persona muestra síntomas respiratorios, la mascarilla será su mejor complemento.
SUPERHÉROES DE LA PROTECCIÓN: En situaciones de alto riesgo de salpicaduras como en kinesioterapia respiratoria, equiparse con guantes, pechera con mangas, escudo facial y lentes protectores es clave.
UN ESPACIO LIMPIO ES UN ESPACIO SEGURO: La limpieza y desinfección regular de superficies no es negociable. Cada rincón cuenta.
DISTANCIA SOCIAL, POR FAVOR: Mantén al menos un metro de distancia entre las camas o en las salas de espera. El espacio personal es clave para prevenir la transmisión.
FONENDOSCOPIOS Y TERMÓMETROS SON PERSONALES: Evita compartir artículos entre pacientes. Si es imprescindible, una buena desinfección es esencial.
PARA LOS EQUIPOS DE TERAPIA RESPIRATORIA: Lo ideal es que sean de uso individual. Si no es posible, un reprocesamiento adecuado garantizará su seguridad.
SI ESTÁS ENFERMO, PROTÉGETE Y PROTEGE A LOS DEMÁS: El personal de salud no es inmune. Si presentas síntomas, el uso de mascarilla es fundamental hasta que mejoren.

SUPERVISIÓN Y EDUCACIÓN CONTINUA: Estar al tanto de las precauciones estándares y adicionales, así como del correcto uso de los elementos de protección personal, es esencial. Un equipo informado es un equipo empoderado.
Este invierno, hagamos de Bupa Chile un ejemplo de prevención y cuidado. Recuerda, cada acción cuenta y juntos podemos hacer una gran diferencia.
¡Vamos por un invierno seguro y saludable para todos!
Bupa Chile 10 |
DR. JUAN FRANCISCO AGUIRRE ASUME COMO RESPONSABLE DE CALIDAD DEL SEGMENTO CLÍNICAS BUPA
CHILE
El Dr. Juan Francisco Aguirre asumió como responsable de Calidad del Segmento Clínicas Bupa Chile a contar del 1 de febrero de este año. Luego de su gran desempeño como subgerente de procesos clínicos en IntegraMédica, el Dr. Aguirre continúa su viaje dentro de la organización, aportando su experiencia y visión en el segmento hospitalario.

Con formación como médico cirujano de la Universidad de Santiago de Chile, un Magíster en Administración de Salud por la Pontificia Universidad Católica de Chile, y un Diplomado en Transformación Digital por la Universidad de Chile, el Dr. Aguirre posee una combinación de conocimientos médicos, gestión de salud y tecnología.
Somos Bupa
3 Clínicas
27 Centros Médicos
300.000 Asegurados
El Dr. Aguirre identifica varios desafíos clave para 2024, incluido el mantener los estándares de acreditación nacional alcanzados, avanzar en la digitalización de los procesos clínicos para optimizar la toma de decisiones y seguir promoviendo la cultura de calidad y seguridad gestionando eficazmente los riesgos clínicos.
Para alcanzar estos objetivos y consolidar la cultura de calidad, el Dr. Aguirre apuesta por la colaboración entre los distintos equipos y áreas de Bupa Chile. Se propone generar más iniciativas de trabajo conjunto, abrir nuevos canales de comunicación para la discusión de desafíos y soluciones diarias, y utilizar más herramientas tecnológicas que fomenten la colaboración y permitan medir el impacto de las acciones de manera continua.
Todo lo anterior teniendo siempre al paciente al centro de todo nuestro quehacer. El propósito es claro: contribuir al objetivo global de Bupa de ofrecer vidas más largas, sanas y felices y un mundo mejor.
LA INCORPORACIÓN DEL DR. JUAN FRANCISCO AGUIRRE SOMERVILLE AL SEGMENTO CLÍNICAS SIN DUDA AYUDARÁ A SEGUIR CRECIENDO EN EL COMPROMISO DE BUPA CHILE CON LA CALIDAD ASISTENCIAL.
Bupa Chile | 11
Bupa Chile 12 |
Bupa Chile | 13 CLÍNICA
SANTIAGO 02
BUPA
NUEVO PUNTO DE ATENCIÓN FONASA EN CLÍNICA BUPA SANTIAGO
En un esfuerzo por optimizar el acceso y enriquecer la experiencia de nuestros usuarios, Clínica Bupa Santiago inauguró el 23 de enero un nuevo punto de atención dedicado exclusivamente a afiliados de FONASA.

La ceremonia de apertura, que contó con la destacada presencia del director de FONASA, Camilo Cid, y el Gerente General de Bupa Chile, Antonio Cantó, se centró en la relevancia de esta alianza entre el sector público y privado para potenciar la accesibilidad sanitaria.
Antonio Cantó enfatizó que este nuevo servicio representa un cambio significativo para los pacientes, alineándose con la misión de Bupa de proporcionar una atención accesible y cómoda. «Los afiliados a FONASA constituyen el 50% de nuestros pacientes y ahora tendrán la posibilidad de vivir una experiencia de atención integrada, desde la compra de bonos hasta la valorización de programas médicos, todo en un solo lugar. Juntos, estamos redefiniendo el estándar de la atención médica, priorizando la humanización y la eficiencia, en pos de una salud más inclusiva y centrada en las personas», afirmó.
La Dra. Paulina Gómez, Gerente Médico Corporativo de Bupa Chile, recalcó el impacto positivo de este punto de atención en la calidad y humanización de la atención para los usuarios de FONASA. «Estamos dedicados a una mejora continua de la experiencia de los pacientes en nuestras clínicas y centros médicos. Este punto de atención está diseñado para hacer más eficientes y cómodos los procesos de gestión y adquisición de bonos».
Por su parte, el gerente general de Clínicas Bupa, Dr. Ignacio Garcia-Huidobro, resaltó la valiosa incorporación de este punto de servicio presencial como una contribución fundamental al bienestar de los pacientes. La nueva propuesta mejorará significativamente la accesibilidad de los usuarios de FONASA, permitiendo la concentración de la compra de bonos en un solo lugar, lo que se traduce en un ahorro considerable de tiempo y esfuerzo.


Operando con tres módulos y un horario de lunes a viernes de 08:00 a 17:00 horas, este punto de atención aspira a que el 70% de los pacientes de Clínica Bupa Santiago utilicen los servicios de FONASA, marcando un hito en el compromiso de Bupa con la calidad y la equidad en la atención médica.
14 | Clínica Bupa Santiago
CONOCE AL EQUIPO DE CIRUGÍA VASCULAR DE CLÍNICA BUPA SANTIAGO
Consolidado en abril de 2021, el equipo de cirugía vascular de Clínica Bupa Santiago, ha elevado el nivel de las intervenciones vasculares, introduciendo tecnologías avanzadas y enfoques mínimamente invasivos para el tratamiento de condiciones complejas.





LA FORMACIÓN ESPECIALIZADA Y LAS HABILIDADES DEL EQUIPO HAN
PERMITIDO INCREMENTAR LA COMPLEJIDAD DE LOS PROCEDIMIENTOS REALIZADOS EN LA CLÍNICA.
COLABORACIÓN Y FORMACIÓN DE EQUIPO
TRABAJO EN EQUIPO: Existe una colaboración estrecha dentro del equipo quirúrgico, con discusión de los casos complejos, lo que permite un enfoque integral y altamente especializado en cada caso.
CAPACITACIÓN CONTINUA: Todos los miembros del equipo están formados y capacitados en técnicas quirúrgicas avanzadas, lo que garantiza un alto nivel de cuidado y resultados óptimos para los pacientes. Se suma a esto la participación permanente en actividades académicas donde se comparte la experiencia del equipo y se aporta a la formación de otros profesionales.
INFRAESTRUCTURA Y APOYO
INSTALACIONES DE PRIMER NIVEL: Clínica Bupa Santiago cuenta con infraestructura y tecnología de vanguardia, incluyendo la instalación próxima de un segundo angiógrafo que permitirá aumentar la capacidad de atención.
ATENCIÓN POSTQUIRÚRGICA Y UNIDADES DE APOYO: La calidad del seguimiento postquirúrgico y la atención en las unidades de apoyo como UTI, UCI y Unidad Coronaria es fundamental para el éxito del tratamiento, siendo un aspecto destacado por el Dr. Cubelli.

El equipo de cirugía vascular de Clínica Bupa Santiago destaca por su enfoque innovador, el uso de tecnología avanzada, y un compromiso con el cuidado del paciente. Este equipo no solo ha elevado el estándar de atención en Chile, sino que también se posiciona como un referente en la cirugía vascular avanzada.
Clínica Bupa Santiago | 15
Dr. Martín Cubelli G Médico Coordinador Cirugía Vascular
Dr. Lucien Chassin-Trubert Cirugía Vascular
Dr. Vicente Rodríguez T. Cirugía Vascular
Dr. Eitan Schwartz Y. Cirugía Vascular
Dra. María Ignacia Villablanca Cirugía Vascular
SANTIAGO REALIZA INNOVADORA CIRUGÍA
VASCULAR BAJO
LA DIRECCIÓN DEL DR. MARTÍN CUBELLI
En un importante hito médico el equipo de cirugía vascular de Clínica Bupa Santiago, liderado por el Dr. Martín Cubelli, ha llevado a cabo una compleja y exitosa cirugía vascular el pasado 10 de febrero, tratando a un paciente de 65 años con un aneurisma de la aorta abdominal. Este caso destacó por su complejidad, dada la ausencia de un cuello aórtico sano y la presencia de aneurismas tanto en las arterias ilíacas comunes como en las hipogástricas.

Utilizando un enfoque mínimamente invasivo, el procedimiento se efectuó mediante dos incisiones inguinales de tan solo 10 mm, marcando un avance significativo en el campo de la cirugía endovascular. El Dr. Cubelli comparó la intervención con el meticuloso proceso de armar un barco dentro de una botella, resaltando la paciencia y precisión requeridas. La elección de dispositivos endovasculares personalizados fue crucial para adaptarse a la anatomía única del paciente, demostrando la importancia de una planificación exhaustiva y la selección cuidadosa de tecnología avanzada.
«Está claro que el éxito en este tipo de casos depende de una extensa planificación, que incluye la toma de múltiples medidas de diámetros y largos y el análisis de los dispositivos endovasculares (endograft) que mejor se adaptan a cada caso en particular, existiendo situaciones en las que los dispositivos disponibles listos para usar (off the shelf) en el mercado no son compatibles con determinadas anatomías, siendo necesario mandar a fabricar dispositivos a medida (custom made)», explicó el Dr. Cubelli.
Este procedimiento no solo subraya la vanguardia tecnológica y la habilidad del equipo de Clínica Bupa Santiago sino también representa un nuevo horizonte en el tratamiento del dolor crónico y enfermedades vasculares complejas, ofreciendo esperanza a pacientes con condiciones previamente consideradas intratables.
Clínica Bupa Santiago 16 | CLÍNICA
BUPA
IMÁGENES TRIDIMENSIONALES
PRE Y POST OPERATORIAS:






del mismo caso, en el segmento abdominal e iliaco, donde se ve el detalle de la embolización del aneurisma hipogástrico derecho y el dispositivo bifurcado iliaco izquierdo (iliac Branch) que permite tratar el aneurisma hipogástrico izquierdo y a la vez preservar la circulación pélvica.
Clínica Bupa Santiago | 17
Imagen del scanner preoperatorio, donde se evidencia el aneurisma toracoabdominal, ilíaco e hipogástrico bilateral.
Imagen postoperatoria panorámica del mismo paciente.
Imagen postoperatoria que corresponde al segmento visceral de la aorta en una reparación de aneurisma toracoabdominal.
Imagen postoperatoria
EQUIPO DE CIRUGÍA MAXILOFACIAL DE CLÍNICA BUPA
SANTIAGO PUBLICA NUEVA TÉCNICA ARTROSCÓPICA PARA EXTRACCIÓN
DE DISCO ARTICULAR
El Dr. Daniel Jerez, subdirector académico y jefe de especialidad de cirugía maxilofacial de Clínica Bupa Santiago, ha marcado un hito con la publicación de su técnica artroscópica para la extracción del disco articular (discectomía) en la Revista Americana de Cirugía Maxilofacial en enero de 2024 (JOMS).
Esta innovación, diseñada para superar los retos de los trastornos temporomandibulares en estados avanzados, promete ser una solución menos invasiva con resultados significativamente positivos. «Esta técnica representa un avance crucial en nuestra búsqueda por tratamientos más seguros y eficaces para los estados más avanzados y degenerativos en trastornos temporomandibulares, minimizando el riesgo para los pacientes y mejorando su calidad de vida», explica el Dr. Jerez.
El desarrollo de esta técnica fue motivado por la necesidad de superar las limitaciones de las cirugías convencionales, tales como las cicatrices, el riesgo de daño al nervio facial y la desvascularización del tejido óseo. A través de un enfoque que demanda habilidades avanzadas en microcirugía y cirugía artroscópica, el Dr. Jerez y su equipo han demostrado cómo la innovación y la educación continua son esenciales para el avance médico.
El equipo multidisciplinario que acompaña al Dr. Jerez en este proyecto incluye a la Dra. Nicole Miranda, neuróloga especialista en manejo del dolor cráneo facial; el Dr. Joaquín Monsalve, anestesista; los cirujanos maxilofaciales Dr. German Laissle y Dr. Carlos Fuenzalida; además de Maximiliano Artigas, kinesiólogo experto en el territorio maxilofacial. Este grupo de profesionales ha sido clave en el éxito y la implementación de la técnica, asegurando un manejo integral y efectivo de los pacientes.

18 | Clínica Bupa Santiago


Revisa en detalle el paper publicado AQUÍ

Este logro no solo refleja un significativo avance para la medicina chilena, sino que también establece un precedente en la comunidad internacional de cirugía maxilofacial, con el Dr. Jerez liderando la vanguardia en la formación y adopción de nuevas técnicas.
Clínica Bupa Santiago | 19
REVERSIÓN DE VASECTOMÍA A TRAVÉS DE MICROCIRUGÍA: UNA NUEVA ESPERANZA PARA FORMAR FAMILIA
En la última década, las operaciones de vasectomía han aumentado en Chile, alcanzando cifras de hasta un 500%, según el Departamento de Estadísticas e Información en Salud (DEIS). Pero, ¿qué sucede con aquellos que se arrepienten de haber pasado por este procedimiento y desean formar una familia nuevamente? Entre el 3% y el 6% de los hombres que se someten a esta intervención eventualmente desean revertirla para recuperar su fertilidad, y Clínica Bupa Santiago es uno de los pocos lugares donde se realiza la microcirugía de reversión de vasectomía.


20 | Clínica Bupa Santiago
El Dr. Gonzalo Valdevenito viajó en 2021 a Cleveland, Estados Unidos, donde realizó un entrenamiento en microcirugía



«La reversión implica reconectar quirúrgicamente los conductos deferentes que fueron cortados durante la vasectomía original», explica el Dr. Gonzalo Valdevenito, urólogo y especialista a cargo de estas cirugías en la clínica, quien comenta que es un procedimiento delicado que requiere mucha precisión y técnica. «Utilizamos un microscopio de doble óptica que magnifica hasta 25 veces el campo operatorio y empleamos suturas extremadamente delgadas, más finas que un cabello humano».
El Dr. Valdevenito señala que la selección de pacientes para este procedimiento se basa en diversos factores, incluyendo el tiempo transcurrido desde la vasectomía original, la edad de la pareja y la presencia de cualquier complicación previa. Estos elementos son cruciales para determinar la viabilidad y el posible éxito de la reversión. «En general, la tasa de éxito ronda el 60%, pero puede llegar hasta el 90%, con tasas de concepción que varían entre el 40% y el 90%. Estas cifras pueden fluctuar dependiendo de factores individuales, como la edad de los pacientes, su estado de salud general, el tiempo transcurrido desde la vasectomía y la edad de la pareja femenina», agrega.
Esta microcirugía, considerada el Gold Standard en reversiones de vasectomía dada su complejidad y las habilidades requeridas para realizarla, se ha transformado en una esperanza significativa para aquellos hombres que desean recuperar su fertilidad después de haberse sometido a una vasectomía.
Clínica Bupa Santiago | 21
Bupa Chile 22 | Clínica Bupa Santiago | 22
BUPA LAB 03
BUPA LAB: COMPROMETIDOS CON LA PREVENCIÓN DEL CÁNCER CERVICOUTERINO
26 de marzo, día mundial de la prevención del cáncer cervicouterino
El cáncer cervicouterino es la segunda neoplasia femenina más relevante en Chile, ya que provoca la muerte de al menos 2 mujeres por día. El principal agente causante de este cáncer es una infección persistente con alguna de las cepas de alto riesgo del Virus Papiloma Humano (VPH).
El VPH es un virus que se puede transmitir con facilidad en una pareja sexual e, incluso, mediante el contacto íntimo de la piel. Según cifras del Instituto de Salud Pública (ISP), en Chile un 16% de las mujeres están infectadas por VPH y cerca de un 45% de ellas por más de una cepa.
Durante muchos años, el tamizaje de cáncer cervicouterino por excelencia se ha basado en el análisis de Papanicolau (PAP), el cual permite detectar alteraciones celulares del cuello uterino mediante una muestra endocervical. Sin embargo, en nuestro laboratorio hemos determinado que en 3 de cada 10 mujeres que reciben un resultado negativo por PAP, ya es posible detectar alguna cepa de VPH de alto riesgo que podría producir cáncer cervical.
La amplificación del material genético del VPH mediante la reacción en cadena de la polimerasa (PCR) ha permitido detectar con muy alta sensibilidad la presencia del virus, por lo cual, este análisis es actualmente el gold standard para su detección y año tras año las solicitudes de PCR han aumentado exponencialmente.
PANORAMA
Examen
Código
Muestra
Genotipos de VPH detectados

BUPA LAB
PCR VPH
303123
Hisopado Endocervical
16, 18, otros de alto riesgo
PCR ampliado de VPH
366951*
Hisopado Endocervical
28, incluyendo los 14 genotipos de alto riesgo
PCR VPH en orina
366966
Orina
32, incluyendo los 14 genotipos de alto riesgo
*La prestación 366951 también está disponible para varones desde muestra de hisopado uretral.
Bupa Lab 24 |
HUMANO
DE DETECCIÓN DEL VIRUS PAPILOMA

Te invitamos a realizarte el moderno y exclusivo examen de Bupa Lab, primer laboratorio en Chile en validar en mujeres una innovadora técnica no invasiva de detección de VPH desde muestras de orina.

Aunque en conjunto el PAP y el PCR de VPH son análisis de bajo costo, en muchos casos, la invasividad del análisis ha llevado a que un 70% de las mujeres no cumpla con sus controles ginecológicos y que un 15% de mujeres sobre 25 años nunca se haya realizado el PAP.
Conscientes de que una prevención efectiva y una detección temprana del cáncer cervicouterino permitiría reducir hasta en un 50% las muertes por esta patología, en Bupa Lab somos pioneros en Latinoamérica en validar una técnica para la detección de VPH desde muestra de orina.
Este análisis es altamente sensible al compararlo con un PCR de muestra endocervical (>94%). Para lograrlo, primero se amplifica el material genético del VPH por PCR y luego este ADN hibrida de forma específica en una matriz. Esta metodología es clave para superar la baja sensibilidad que se consigue solo con un PCR tradicional.
La toma de muestra para esta nueva técnica es completamente indolora y puede ser tomada por la misma paciente para resguardar su intimidad. Este nuevo análisis permitirá llegar a una gran proporción de mujeres que quiere cuidar su salud de forma rápida, simple y sin dolor.
Bupa Lab | 25
ACTUALIZACIÓN SOBRE LA DETECCIÓN DE VIRUS
RESPIRATORIOS Y SARS-CoV-2 EN LABORATORIO BUPA LAB DE BUPA CHILE

Durante la semana epidemiológica Nº 11 del año 2024, el laboratorio Bupa Lab de Bupa Chile reportó la detección de 31 casos positivos de virus respiratorios, comportamiento superior a las semanas anteriores que se obtuvieron en promedio 17 casos. Entre los virus identificados, el el Rhinovirus/Enterovirus fue el más frecuente con 19 casos, seguido por 8 casos de Influenza A, 2 Coronavirus no covid, 1 Adenovirus y 1 Bocavirus.
Desde el año 2023, Bupa Lab ha implementado el uso del Panel Virus Respiratorio Molecular (código Fonasa 306122), destacando sus ventajas frente a la técnica de inmunofluorescencia. Este panel permite la detección de un espectro más amplio de virus respiratorios, ofreciendo mayor sensibilidad gracias a su base en biología molecular. Además, el laboratorio procesa muestras dos veces al día, de lunes a domingo, lo que facilita la disponibilidad de resultados el mismo día o al día siguiente de su recepción. El copago para pacientes Fonasa es de $40.090, menor en comparación con los $46.250 de la inmunofluorescencia.
Esta actualización subraya el compromiso continuo de Bupa Lab con la salud pública, mediante la implementación de tecnologías avanzadas para la detección precisa y oportuna de virus respiratorios y SARS-CoV-2.
SARS-CoV-2
Se mantiene como el principal virus detectado por el laboratorio.
303 casos confirmados
706 pacientes analizados
41,6%
42,9% incremento en la tasa de positividad desde la semana epidemiológica Nº 1 del 2024. DEL AL
Bupa Lab 26 |
Bupa Lab | 27
VIRUS RESPIRATORIOS
BUPA
Metropolitana 2024
CoV-2 NÚMERO DE MUESTRAS PROCESADAS CON RESULTADOS POSITIVOS, NEGATIVOS Y % DE POSITIVIDAD POR SEMANA EPIDEMIOLÓGICA Bupa Lab 2024 n° de virus detectados 40 20 0 n° de semana del año 2024 01 02 03 04 05 06 07 08 11 09 10 Rinovirus-Enterovirus Bocavirus Coronavirus NO COVID Adenovirus Parainfluenza Influenza A n° de resultados positivos y negativos 750 500 250 0 n° de semana del año 2024 01 02 03 04 05 06 07 08 11 09 10
IDENTIFICACIÓN
|
LAB Región
SARS
Positivos Negativos
CULTIVO ANAEROBIO DISPONIBLE EN BUPA LAB
El cultivo anaerobio desempeña un papel crucial en el diagnóstico y tratamiento de una amplia gama de enfermedades infecciosas.

Estos microorganismos pueden estar implicados en infecciones graves, como abscesos intraabdominales, infecciones de heridas quirúrgicas y bacteriemia.
Dado que las bacterias anaerobias pueden ser parte de la microbiota normal del cuerpo humano, su presencia en muestras clínicas puede ser indicativa de un proceso infeccioso subyacente.
La falta de reconocimiento y tratamiento de infecciones anaerobias puede llevar a complicaciones graves, como la propagación de la infección, la formación de abscesos, la sepsis y, en casos extremos, la muerte del paciente.
Por lo tanto, la capacidad de identificar y tratar eficazmente las infecciones anaerobias mediante el cultivo anaerobio es esencial para una práctica médica efectiva y para mejorar los resultados clínicos de los pacientes.
Tenemos a disposición en Clínica Bupa la realización de cultivo anaerobio para:
• Tejidos en medio de transporte Swab
• Muestra líquida en vial Portagem
Recordar que se deben evitar las muestras con tórulas y muestras superficiales. Código cultivo anaerobio: 306012.
Bupa Lab 28 |
MUESTRAS ACEPTABLES Y NO ACEPTABLES CULTIVO ANAERÓBICO
SITIO
MUESTRAS ACEPTABLES
Absceso o aspirado obtenido por jeringa luego de desinfección de superficie
MUESTRAS INACEPTABLES
Materia superficial obtenido por torula: oído, ocular, encías, nariz, nasofaríngeo, amígdalas.
CABEZA Y CUELLO
PULMÓN
Tejido/biopsia obtenida por cirugía o colección por radiología intervencionista
Aspirado seno nasal
Muestra por broncoscopía obtenida por cepillo protegido
Punción percutánea pulmonar
Líquido pleural
Tejido/biopsia, por cirugía
Absceso o aspirado obtenido por jeringa
Expectoración o esputo inducido
Lavado broncoalveolar
Secreción endotraqueal (aspirado)
Cualquier muestra tomada con torula
SNC
Tejido/biopsia obtenida por cirugía
LCR
Absceso o aspirado obtenido por jeringa o drenaje percutáneo
Cualquier muestra enviada en tórula sin medio de transporte anaeróbico
ABDOMEN
Bilis
Líquido peritoneal obtenido por jeringa
Tejido/biopsia, por cirugía
Orina por punción suprapúbica
TRACTO URINARIO
TRACTO GENITAL MASCULINO
TRACTO GENITAL FEMENINO
Absceso o aspirado obtenido por jeringa
Absceso o aspirado obtenido por jeringa
Culdoscopía
Aspirado endometrial obtenido por succión o colector protegido
Tejido/biopsia obtenida por cirugía
DIU para Actinomyces
Aspirado por aguja de líquido sinovial y médula ósea
Orina espontánea (1er o 2do chorro) o por cateterismo
Orina
Secreción uretral
Semen
Líquido o secreción prostática
Muestra cervical, vaginal, vulvar, perineal Loquios
HUESOS Y ARTICULACIONES
TEJIDOS BLANDOS
Tejido/biopsia obtenida por cirugía
Dispositivo protésico extraído
Aspirado obtenido por jeringa o drenaje percutáneo
Aspiración profunda de heridas abiertas luego descontaminación superficie
Material superficial tomado por torula
Material superficial coleccionado de superficie piel o bordes de herida
Bupa Lab | 29
INTEGRAMÉDICA 04
INTEGRAMÉDICA PLAZA VESPUCIO
PONE EN MARCHA
PROGRAMA
PILOTO TEA
Con el firme propósito de ofrecer una atención médica más inclusiva y especializada, IntegraMédica Plaza Vespucio ha dado un paso adelante con la implementación de su programa piloto TEA (Trastorno del Espectro Autista), iniciado el 27 de febrero de 2024. Este programa representa un avance significativo en la atención sanitaria, respondiendo a una necesidad creciente de servicios especializados para personas con TEA y sus familias.


IntegraMédica 32 |
El desarrollo de este programa piloto ha sido posible gracias a la formación de un equipo multidisciplinario desde el 9 de enero, compuesto por neurólogos infantiles, psicólogos y fonoaudiólogos, quienes se han dedicado a proporcionar una atención integral que abarca más allá de las consultas médicas. Este esfuerzo colectivo busca no solo mejorar la calidad de atención de los pacientes, sino también cumplir con el marco legal actual de la Ley TEA 21545, consolidando a IntegraMédica Plaza Vespucio como un centro médico inclusivo en neurodiversidad.
Este programa representa un compromiso profundo con la inclusión y la excelencia en la atención médica.
La Dra. Cristina Rauchfuss, Directora Médica de IntegraMédica Plaza Vespucio, compartió su visión sobre el programa: «Este programa representa un compromiso profundo con la inclusión y la excelencia en la atención médica. Nuestro objetivo no es solo cumplir con un mandato legal, sino ir más allá, creando un entorno de cuidado integral que responda de manera efectiva a las necesidades de nuestros usuarios con TEA y sus familias, asegurando que se sientan comprendidos, respetados y valorados en cada interacción con nuestro centro».
Este programa piloto destaca por su enfoque holístico, que incluye no solo al personal de salud en atención directa del paciente, sino también a todo el equipo del centro médico, desde administrativos hasta servicios generales. Se han implementado diversas iniciativas, como el ingreso con acceso expedito, cajas de calma en distintos pisos para situaciones de descompensación, y áreas de juegos didácticos en las salas de espera, todo ello pensado para ofrecer un ambiente acogedor y seguro para los usuarios y sus familias.
IntegraMédica tiene previsto evaluar el impacto y el éxito de este programa a través de un sistema de seguimiento que incluye la activación de arribo prioritario y el seguimiento telefónico de los pacientes para recoger sus impresiones y sugerencias. Este feedback será crucial para ajustar y mejorar el programa antes de su posible expansión a otros centros, asegurando que la experiencia de los pacientes sea siempre positiva y enriquecedora.
IntegraMédica | 33

IntegraMédica 34 |
DRA. JOSEFINA BASCUÑÁN: NUEVA LÍDER EN GESTIÓN CLÍNICA DE INTEGRAMÉDICA
El pasado 11 de marzo se incorporó al equipo la Dirección Médica de IntegraMédica la Dra. Josefina Bascuñán. Con una trayectoria profesional distinguida y un compromiso con la excelencia en el ámbito de la salud, la Dra. Josefina asume rol fundamental para seguir trabajando por mejorar la calidad y la eficacia de los servicios de IntegraMédica.

La Dra. Bascuñán es Médico Cirujano graduada de la Universidad de Chile, con una Maestría en Salud Pública de la misma institución y un MSc en International Health Management del Imperial College London. Su carrera se ha centrado en el avance de la salud pública y la gestión sanitaria, tanto a nivel nacional como internacional. Ha liderado proyectos significativos en el Ministerio de Salud de Chile y ha desempeñado roles estratégicos en la ACHS y el Hospital del Trabajador de Santiago. Su experiencia se complementa con un conocimiento académico, reflejado en su labor como profesora universitaria y su participación en importantes proyectos de investigación.
«Estoy muy contenta de incorporarme a este gran equipo y espero ser un aporte significativo para el trabajo y la misión que tiene el área de la Gestión Clínica en IntegraMédica».
Además de su trayectoria profesional, Josefina comparte una pasión por el ballet clásico, un hobby que ha practicado desde muy joven, mostrando su dedicación y disciplina tanto en su vida profesional como personal.
¡Desde IntegraMédica, le deseamos mucho éxito en este nuevo desafío!

IntegraMédica | 35

IntegraMédica 36 |
INTEGRAMÉDICA CONMEMORA EL MES DE LA MUJER: FORTALECIENDO LA SALUD FEMENINA
En el marco del Mes de la Mujer, IntegraMédica se ha comprometido a fortalecer la salud femenina a través de diversas iniciativas y eventos para generar conciencia sobre el cuidado de la salud de las mujeres.
Uno de sus eventos más destacados fue un live de Instagram que contó con la participación del Dr. Omar Nazzal, jefe técnico de Ginecología y Obstetricia de IntegraMédica, y la reconocida comunicadora Claudia Conserva quienes brindaron una entretenida conversación y respondieron las preguntas que fueron dejando los usuarios conectados.
Durante la transmisión, se discutieron temas fundamentales, incluyendo la importancia de los chequeos ginecológicos regulares, el método adecuado para realizar un autoexamen de mama y la relevancia del examen Papanicolau (PAP) y la mamografía en la detección temprana del cáncer, una experiencia que toca muy personalmente a Claudia ya que ella tuvo cáncer hace unos años atrás.
Además de estos temas, se compartieron consejos prácticos para que las mujeres puedan enfrentar estos procedimientos con mayor comodidad y tranquilidad. Junto con ello, durante el mes de marzo, ofrecimos beneficios exclusivos para las mujeres, accediendo mamografías y consultas ginecológicas más PAP a un costo accesible.
Todas estas iniciativas y actividades tienen como objetivo generar una cultura de cuidado y prevención en la salud de las mujeres, que van de la mano con la misión de IntegraMédica que busca cuidar y apoyar a sus pacientes no solo cuando requieran cuidados de salud, sino que desarrollar innovadoras iniciativas centradas en la prevención de enfermedades y en la promoción de hábitos de vida saludables.


Revive el LIVE AQUÍ IntegraMédica | 37

IntegraMédica 38 |
INTEGRAMÉDICA
ALTO LAS CONDES FORTALECE EL DIAGNÓSTICO POR IMAGEN CON NUEVO RESONADOR 1.5 TESLA
En un esfuerzo por mejorar la calidad de los diagnósticos y tratamientos ofrecidos a sus pacientes, IntegraMédica Alto Las Condes ha incorporado un nuevo resonador de última generación. Con esta instalación el centro médico contará a partir de ahora con dos resonadores magnéticos de 1.5 Tesla, elevando el estándar en la precisión diagnóstica y comodidad del paciente.
La Dra. Cristina Rauchfuss, directora médica de IntegraMédica Alto Las Condes, destaca que este avance no solo amplía significativamente la capacidad del centro para realizar una amplia gama de exámenes diagnósticos, incluidos estudios neurológicos, musculoesqueléticos, de cuerpo entero y, próximamente, mamarios, sino que también mejora la experiencia del paciente. Gracias a la potencia de 1.5 Tesla de los resonadores, los exámenes se realizan en menos tiempo, lo que resulta en un proceso más cómodo y eficiente.
Este logro es parte de un esfuerzo continuo por ofrecer diagnósticos más precisos y rápidos, contribuyendo a una reducción significativa en el tiempo de espera y en la duración de los procedimientos para los pacientes. Es especialmente relevante para aquellos que pueden encontrar el proceso de resonancia magnética incómodo.
La integración del nuevo resonador ha representado un desafío tanto técnico como humano para el equipo de IntegraMédica Las Condes, que se ha preparado para comenzar a trabajar con el equipo a mediados de abril.

Este avance se complementa con la reciente inauguración de la unidad de Medicina del Deporte en enero, reforzando el compromiso de IntegraMédica Alto Las Condes con la innovación médica y el cuidado integral de la salud. La unidad ofrece desde evaluaciones especializadas hasta rehabilitación kinesiológica, apoyando a pacientes de todos los niveles, desde aficionados hasta atletas profesionales.
La implementación del nuevo resonador y la creación de la unidad de Medicina del Deporte destacan el compromiso de IntegraMédica Alto Las Condes con la innovación médica y el cuidado de la salud de las personas.
IntegraMédica | 39
CLÍNICA BUPA REÑACA 05
ESCENARIO DE SIMULACIÓN CLÍNICA: MANEJO INICIAL DE SHOCK SÉPTICO PEDIÁTRICO
Para asegurar una atención humanizada y de calidad en Clínicas Bupa siempre estamos

Durante marzo la unidad de Pediatría y Urgencias del equipo de Clínica Bupa Reñaca, participó en el entrenamiento de manejo inicial de shock séptico pediátrico, a través de un escenario de simulación clínica de alta fidelidad.
En la instancia los profesionales pudieron poner en práctica sus conocimientos a través del uso de un fantoma pediátrico de última generación para recrear el escenario asociado a esta patología.
En la actividad los profesionales se vieron enfrentados a la toma de decisiones rápidas y efectivas, siguiendo el protocolo establecido y siempre con la salud y el bienestar del paciente en el centro.

Clínica Bupa Reñaca 42 |



CLÍNICA BUPA
REÑACA DESTACADA EN RANKING WORLD BEST HOSPITALS 2024
En una noticia que resalta el compromiso continuo con la excelencia y la calidad en la atención de salud, Clínica Bupa Reñaca se ha ubicado en el prestigioso puesto número 22 dentro del ranking de los mejores hospitales de Chile, según el ranking World Best Hospitals 2024. Este logro no solo subraya nuestra posición como el principal prestador privado regional sino que también nos distingue en el escenario nacional e internacional de la salud.
World Best Hospitals 2024 es una medición internacional de alta relevancia en el ámbito de la salud, que ha incluido por primera vez a nuestro país en un análisis que considera más de 30 países. Se fundamenta en criterios rigurosos que incluyen la opinión de profesionales del sector, encuestas de satisfacción de pacientes, calidad de la atención médica e infraestructura, entre otros factores clave.
Este reconocimiento en un reflejo de nuestra labor diaria para entregar salud oportuna y de calidad a nuestros pacientes, con la mejor infraestructura de alta resolutividad en regiones y un grupo de especialistas de primer nivel.
En Bupa, este logro reafirma nuestro propósito de ayudar a las personas a tener vidas más largas, sanas y felices, mientras trabajamos incansablemente por crear un mundo mejor. Celebramos este importante reconocimiento con nuestros pacientes, equipo médico y todos los que forman parte de nuestra comunidad, reiterando nuestro compromiso de seguir elevando los estándares de calidad en la atención de salud que brindamos.
Clínica Bupa Reñaca | 43
TRANSFORMANDO EL MANEJO DEL DOLOR: CLÍNICA
BUPA REÑACA LIDERA CON LA BOMBA INTRATECAL
Clínica Bupa Reñaca se ha posicionado como líder en el tratamiento del dolor refractario en Chile, gracias a la implementación de la bomba intratecal, un dispositivo que representa un avance significativo en el manejo del dolor, especialmente para pacientes con cáncer. Este centro médico, que inició la aplicación de este tratamiento hace ocho años, es hoy el único en la región y uno de los pocos a nivel nacional que cuenta con la especialización y experiencia necesarias para la implantación y manejo de estas bombas.


Clínica
44 |
Bupa Reñaca
Imagen corresponde a Bomba Tricumed, modelos IP2000V y la IP1000V.
Estas bombas son sistemas de infusión intratecal de flujo fijo, diseñadas para la administración controlada de medicamentos directamente en el espacio intratecal.



La bomba intratecal se distingue por permitir la administración directa de medicamentos, como la morfina, en el espacio intratecal, lo que maximiza el efecto analgésico y minimiza los efectos secundarios asociados con dosis más altas necesarias en administraciones sistémicas. Este procedimiento se ha convertido en una alternativa crucial para pacientes cuyo dolor crónico no responde a los tratamientos convencionales, ofreciendo un alivio significativo y mejorando su calidad de vida.
Nuestra experiencia nos ha demostrado que la bomba intratecal no solo alivia el dolor de manera efectiva, sino que también devuelve a los pacientes una parte de su vida que el dolor les había quitado.
El éxito de este tratamiento en Clínica Bupa Reñaca es el resultado del trabajo de un equipo multidisciplinario de especialistas, incluyendo al Dr. Cristóbal Carrasco y la Dra. Constanza Rojas, anestesiólogos expertos en dolor crónico e intervencionismo; Dr. Rodrigo Valenzuela, traumatólogo especializado en cirugía de columna, y personal de anestesia y arsenalero dedicado a procedimientos de dolor crónico intervencional. Entre los especialistas destacan el Dr. Cristóbal Carrasco
Los principales beneficios de la bomba intratecal para los pacientes incluyen la reducción significativa del dolor
crónico, una mejora notable en la calidad de vida, y la reducción de los efectos colaterales indeseables asociados con medicamentos para el dolor administrados por otras vías. Además, la bomba, que se implanta bajo la piel del abdomen y está conectada a un catéter que libera medicación de manera continua, ofrece a los pacientes una mayor autonomía y la posibilidad de llevar una vida más activa y satisfactoria.
«Nuestra experiencia nos ha demostrado que la bomba intratecal no solo alivia el dolor de manera efectiva, sino que también devuelve a los pacientes una parte de su vida que el dolor les había quitado», afirma el Dr. Cristóbal Carrasco, anestesiólogo especialista en dolor crónico e intervencionismo.
Clínica Bupa Reñaca subraya la importancia de la implantación precoz de la bomba intratecal, argumentando que un enfoque temprano en el manejo del dolor puede prolongar significativamente la calidad de vida del paciente, brindando no solo alivio del dolor sino también dignidad en el proceso de tratamiento.
Clínica Bupa Reñaca | 45
CLÍNICA BUPA ANTOFAGASTA 06
CLÍNICA BUPA
ANTOFAGASTA Y SU CRUCIAL APOYO EN EL OPERATIVO
MÉDICO «MANOS
QUE AYUDAN»
Clínica Bupa Antofagasta ha jugado un rol fundamental en el éxito del operativo médico «Manos que Ayudan», una iniciativa liderada por la Fundación Manos que Ayudan, que ha permitido realizar cirugías a 25 mujeres de Antofagasta, Calama y Huépil. Este esfuerzo conjunto ha proporcionado un acceso a tratamientos quirúrgicos especializados en prolapsos, histerectomías e incontinencia urinaria para mujeres en situación de vulnerabilidad socioeconómica.
A través de un sistema de postulación en redes sociales, la Fundación ha podido identificar y seleccionar a pacientes necesitadas de estas intervenciones, ofreciendo subsidios parciales o totales para cubrir los costos. Esta estrategia ha facilitado una rápida respuesta a las necesidades médicas urgentes, destacando el compromiso de la Clínica Bupa Antofagasta con la salud y el bienestar de las mujeres de la región.
El Dr. Mcjohn Vicuña, ginecólogo-oncólogo y presidente de la Fundación, encabezó personalmente las cirugías, apoyado por un equipo médico de la Clínica Bupa Antofagasta. La culminación de este operativo se celebró en un emotivo encuentro entre los pacientes, sus familias y el equipo médico, resaltando las historias de cambio y recuperación.
Pacientes como Dániza Álvarez y Gladys Araya compartieron sus experiencias


Clínica Bupa Antofagasta 48 |








personales, enfatizando la impactante diferencia que este operativo ha hecho en sus vidas. Álvarez, por ejemplo, descubrió la iniciativa a través de un video en TikTok y se sometió a una operación para corregir un prolapso uterino severo. Su historia es un ejemplo del efecto transformador de estos procedimientos y del acceso mejorado a la atención médica que la Fundación y la Clínica han facilitado.
Clínica Bupa Antofagasta junto con la Fundación Manos que Ayudan, han demostrado una dedicación excepcional a mejorar la salud de las mujeres en Chile, especialmente aquellas que enfrentan barreras para acceder a tratamientos en el sistema público o privado. Con más de 250 operaciones realizadas en los últimos siete años, la Fundación subraya la importancia de la colaboración y el apoyo comunitario en la atención sanitaria.
Este operativo médico es una clara muestra del impacto positivo que se puede lograr cuando las instituciones médicas privadas y las organizaciones sin fines de lucro trabajan juntas hacia un objetivo común. La Clínica Bupa Antofagasta continúa siendo un pilar esencial en la provisión de cuidados de salud accesibles y de alta calidad, invitando a más mujeres con problemas ginecológicos a participar en futuros operativos y a recibir el apoyo y atención que merecen.
Clínica Bupa Antofagasta | 49